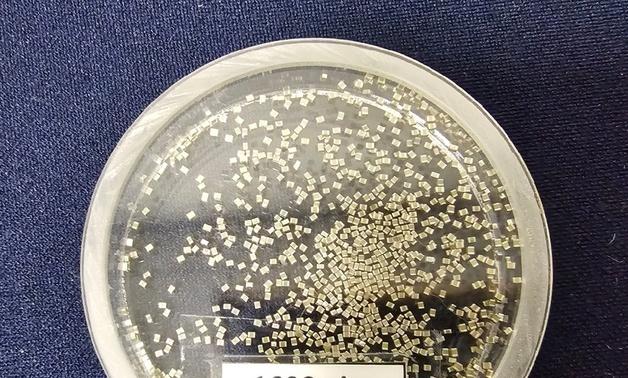
삼성전기, AI용 MLCC 가격 인상 가능성…13% 강세[핫종목]
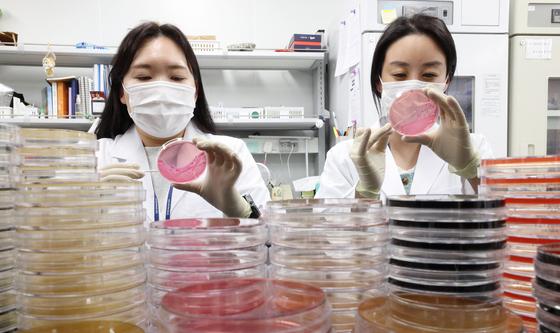
'때이른 무더위 식중독 조심하세요'

美대법, 트럼프 상호관세 위법 판결…韓 등 무역합의 파장
미국 연방대법원이 20일(현지시간) 도널드 트럼프 미국 대통령이 지난해 한국을 비롯해 전 세계 주요 교역국에 부과한 상호관세에 대해 위법 판결을 내렸다.대법원은 이날 6 대 3으로 트럼프 대통령이 상호관세를 부과한 근거로 1977년 제정된 국제비상경제권한법(IEEPA)을 활용한 것이 권한을 넘어섰다고 판단한 결론을 최종 확정했다.트럼프 행정부는 지난해 2월 IEEPA를 근거로 중국, 멕시코, 캐나다를 상대로 소위 '펜타닐 관세'를 부과했다. 또